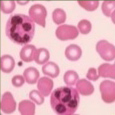
ヘマチン

アンアミおすすめプロダクト
特集コンテンツ SPECIAL CONTENTS

美容室でのシャンプーやトリートメントはたくさんありすぎて何を選んでいいかわからない…
そんなお客様のご意見を多数耳にしたことがあります。
そもそもオススメされるものって
どんなものがあるの?
例えば、シンプルで買い求めやすい価格なことから人気を集めているブランドや、
ナチュラル志向のブランドのもの、ケミカルに対応したものなど色々なニーズに合った商品があります。
今回はそんなおすすめプロダクトを
5つご紹介します。
お客様一人一人のお悩みは担当スタイリストにご相談してみてください♫
きっとオンリーワンの商品が見つかるはずです!
PICKUP-PRODUCT
E STANDARD
イイスタンダード

- イイスタンダード シャンプー
- 250ml ¥3,080
- 600ml ¥5,280
スキンケアクオリティーのヘアケアで
髪が美しく変わっていく感動をより多くの方へ。
このシリーズの一番良いところは「95%以上が美容成分&極上の香りのヘアケア」ということ。
肌、髪の毛に優しいのはもちろん、高級感あふれる作りと内容にこだわったこちらの商品はオーガニック兼ケミカルに対応している商品の一つとなっています。
お客様の髪の毛にあったものはもちろん、女性専用に作られているスキャルプ系のシャンプーも人気の一つ。泡立ちも滑らかです。
こんな方に
オススメ
カラー、パーマなどの施術ダメージをケアしたい方
9種の精油が髪と頭皮に潤いを与えます
9種の植物エキス

- アルニカ

- ゴボウ

- オランダカラシ

- セイヨウキヅタ

- ニンニク

- ローマカミツレ

- オドリコソウ

- マツ

- ローズマリー
13種類の厳選された美容成分

- サクシニルアテロコラーゲン(魚)

- 加水分解ケラチン
- ヘマチン

- リン酸アスコルビルMg/ビタミンC誘導体

- ヒアルロン酸

- フラーレン

- ベジタミド

- 浸透型コラーゲン

- クレアチン

- フェザーケラチン(水鳥)

- 吸着型コラーゲン

- ハイブリッドシルクポリマー

- メドウフォーム油
PICKUP-PRODUCT
YELLOW
NATURAL
PRODUCT
イエロー
ナチュラルプロダクト

- イエローナチュラルプロダクト
- 250ml ¥3,080
- 600ml ¥5,280
洗うだけではなく、
スキンケアするように頭皮にも美容成分を。
Natural × Science 。ナチュラル × サイエンスをコンセプトとして掲げる従来のシャンプートリートメントの概念を打ち破った新シャンプー。
「頭皮ケア」に着目したオイルシャンプーという選択。洗うだけではなく、スキンケアするように頭皮にも美容成分を。”自然と科学のバランス”で土台となる頭皮から潤し整え、1日の疲れを癒す。organicならではの5つのオーガニック精油を配合。オシャレでオーガニック好きにはオススメしたい商品です。
こんな方に
オススメ
頭皮の乾燥が気になる方
根本から髪の毛を綺麗にしていきたい方
頭皮のハリがない、抜け毛・薄毛が気になる方
深く心を緩ませる香り
5つのオーガニック精油

- ティーツリー

- ユーカリ

- グレープフルーツ

- オレンジ

- ラベンダー
不使用成分
- ×鉱物油
- ×シリコン
- ×パラベン
- ×石油系界面活性剤
- ×合成香料
- ×合成着色料
- ×動物性原料
着目したのはウチワサボテンオイルの力、
砂漠を生き抜くアンチエイジング効果
- 保湿力
- 抗酸化
- 再生
砂漠の過酷な乾燥や紫外線から自らを守るため、並外れた保水力と栄養を持つウチワサボテン。
その種子から抽出したオイルは、アルガンオイルを超える「保湿力」と「抗酸化力」を秘め、
幻のオイルと呼ばれています。
- リノール酸
肌にハリを与え、潤いをキープ。(アルガンオイルの約1.8倍)
- ビタミンE
抗酸化作用に優れ、サビない肌へ。(アルガンオイルの約1.6倍)
PICKUP-PRODUCT
ideal
イデアル

- ミエル
シャンプー&トリートメント - シャンプー250ml ¥2,750
- トリートメント280g ¥2,750
毎日のシャンプーで髪のダメージを補修し、
美しい髪へ導きます。
mielシャンプー・トリートメントは4つの補修・保護成分で、髪にハリ・コシ・潤いを与えます。さっぱりとした洗い上がりの使用感と潤いを両立し、ダメージヘアにもおすすめです。
mielシャンプーの特徴は「洗い上がりさっぱり、潤い長持ち」。ラベンダー&オレンジの香りで爽やかな香りが特徴。mielトリートメントの特徴は「植物オイル配合・潤い長持ち」香りはシャンプーと同様です。
主要成分:コラーゲン・ケラチン・コメタンパク・クレアチン
こんな方に
オススメ
カラー、パーマなどの施術ダメージをケアしたい方
9種の精油が髪と頭皮に潤いを与えます
9種の精油

- ラベンダー

- オレンジ

- ライム

- ユーカリ

- パルマローザ

- ハッカ

- ニオイテンジクアオイ

- アトラスシーダー樹脂

- エンピツビャクシン
- 美容成分たっぷり
コラーゲン・ケラチン・コメタンパクが、毛髪内部からダメージ補修。潤いに満ちた美しい髪へ。
- クリーミーな泡
美容成分をたっぷり含んだ泡は、もっちりときめ細やか。毛髪全体を優しく包みます。
- 頭皮さわやか
アミノ酸&ベタイン系の洗浄剤を使用。潤いを保ちながらすっきりと清潔に洗い上げます。
PICKUP-PRODUCT
SUBLIMIC
AQUA INTENSIVE
サブリミック
アクアインテンシヴ

- サブリミック アクアインテンシヴ
- 250ml ¥2,860
- 500ml ¥4,400
高まる密度、満ちるうるおい。ダメージケアのその先へ。
髪のダメージ要因にアプローチする「ダブルリペアシステム」が、ダメージケアを次のステージへと進めました。使うたびに、芯から高まる密度、満ちるうるおいがオススメの理由です。
ダメージを受けている髪に、芯から負けない強さに髪の毛を導いてくれるのもポイント。
こんな方に
オススメ
カラー、パーマなどの施術ダメージをケアしたい方
先端の知見とテクノロジーを応用し、
アジア女性の「美しさを高める力」を最大限に引き出します
-

- 毛髪形状ケアテクノロジー
- ダメージによる毛髪形状の乱れに着目
毛髪のダメージはキューティクルや毛髪内部の損傷だけでなく1本1本の形状にまで影響していることを発見。
乱れのないなめらかな形状にまで補正するというダメージケアの新概念となるテクノロジーを開発しました。
-

- モイスチャークリエーティングテクノロジー
- 肌が自らうるおいを産生するメカニズムの発見
資生堂は長年の肌研究の中で、「NMF(天然保湿因子)」が肌の中で生成されるメカニズムを発見しました。
一人ひとりの肌に備わる「自らうるおう力・バリア機能を高める力」の源を解き明かした先進の研究成果です。
-

- 大気汚染物質から髪と頭皮を守る
- 肌が自らうるおいを産生するメカニズムの発見
髪と頭皮を取り巻く外的環境に着目。資生堂独自のテクノロジーを採用し、髪のダメージや頭皮トラブルの原因となる空気中に浮遊するPM2.5や花粉を寄せ付けないようにします。
-

- ポジティブエレメント
- 香りの効果を「実証」するサイエンスを追究
資生堂は表情解析技術を用いて感情を測定し、香りの効果実証に応用しています。この研究から、香りをかいだ人の「幸せな気持ち」指数の測定結果にもとづいた、明るく前向きな、笑顔になれる香り「ポジティブエレメント」を開発しました。
PICKUP-PRODUCT
THE GROOMING
ザ グルーミング

- ザ グルーミング
- シャンプー 120ml ¥1,650/500mL ¥4,620
- トリートメント 60g ¥1,100/500g ¥6,050
髪や肌におだやかに効く、
こだわり処方。
髪のダメージ要因にアプローチする「ダブルリペアシステム」が、ダメージケアを次のステージへと進めました。使うたびに、芯から高まる密度、満ちるうるおいがオススメの理由です。
ダメージを受けている髪に、芯から負けない強さに髪の毛を導いてくれるのもポイント。
こんな方に
オススメ
頭皮のベタつき、ニオイ、フケやかゆみ、細毛や薄毛、油っぽい肌感、
シェービングによる乾燥や肌荒れなど
男性ならではの髪や肌の悩みを解決します
- 頭皮環境ケア
髪を育てるには、まず髪の土台となる頭皮のケアが重要。過剰に分泌された皮脂を抑え、汚れもしっかりと取り除きます。
- 育毛ケア
男性特有のヘアサイクルに着目。ヘアサイクル内の成長期を延長させ、髪の退行期を抑制します。
- エクスターナルケア
シャンプーとトリートメントを併用して使うことで、ドライ直後から髪のボリュームアップ感を実感! 思い通りのスタイリングがきまる髪に導きます。

心地よい香りのエッセンシャルオイルを配合
パチュリ・ユーカリ・イランイランなどをベースにヒノキ・完熟柚子・お香などに使われる沈香を使用。それに加え、個性のある男らしさを印象付けるウッディ・ハーバルも調合しています。皮脂や汗のにおいを抑えながらも、心地よい香りでリラックスできます。
エッセンシャルオイル

- ユーカリ

- イランイラン

- パチュリ

- 柚子

- セダーウッド

- ガイアックウッド

- 沈香

- ヒノキ
サロンリスト SALON LIST
-
アンアミ渋谷
TEL03-6455-0960
-
アンアミ表参道
TEL03-5774-1011
-
ジョエミ新宿
TEL03-3355-1011
-
アンアミ吉祥寺
TEL0422-23-7073
-
パーク志木
TEL048-424-4101




